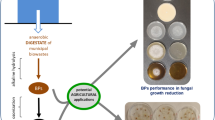

Abstract
Aim
This study aims to evaluate the impact of seed primimg with soil microorganism on the germination and metabolism of pearl millet seeds when exposed to the allelopathic effects of some specific weed extracts.
Methods
Pearl millet seeds were categorized into five distinct groups. Four of these groups were subjected to priming with different soil microorganisms: Bacillus velezensis, Pseudomonas fluorescens, Serratia marcescens, and Trichoderma viride. The remaining, fifth group underwent hydropriming. Subsequently, these groups were subjected to germination in the presence of weed extracts, a process that extended over five days. Following germination, various factors were assessed, including germination percentage, radicle and plumule length, and seed vigor. Furthermore, the study encompassed the analysis of biochemical parameters such carbohydrate and phytate hydrolysis, oxidative stress markers, antioxidant enzyme activity, and secondary metabolite.
Results
The findings of the study revealed that biopriming of pearl millet seeds with soil microorganisms led to a significant enhancement in germination, even when exposed to different weed extract treatments. This improvement was chiefly manifested through heightened levels of antioxidant enzymes, which mitigate the oxidative stress induced by the weed treatments. Moreover, the biopriming process improved the hydrolysis in germinated seeds, resulting in energy savings and a reduction in carbon utilization for secondary metabolism through the shikimic acid pathway and the phenylpropanol pathway. This facilitated the production of defense molecules like phenols and flavonoids.
Conclusion
Seed priming with soil microorganism ultimately bolsters the seeds’ tolerance against allelochemicals originating from weed residue treatments.
Similar content being viewed by others
Explore related subjects
Discover the latest articles, news and stories from top researchers in related subjects.Avoid common mistakes on your manuscript.
Introduction
In the modern era, the global climate change phenomenon presents a substantial risk to food crop production. Researchers are actively searching for stable crops that can withstand climate change conditions while retaining their high nutritional value (Vambe et al. 2023). Among these promising crops, pearl millet stands out due to its nutritional richness and inherent ability to thrive in challenging environmental conditions, including low rainfall, poor soil fertility, high temperatures, and drought. These attributes make it a viable candidate to potentially replace staple crops like corn, wheat, and rice (Singhal et al. 2022; Pandey and Bolia 2023).
Millet crops flourish during hot and humid rainy seasons, which unfortunately create an ideal environment for the rapid spread of weeds. These invasive plants cause loss in the crop yield. Weeds often compete with pearl millet for essential resources such as water, nutrients, and sunlight. The allelopathic chemicals released by weeds can further intensify this competition, affecting the ability of pearl millet to access the resources it needs for growth (Samota et al. 2022; Chinyo et al. 2023). Allelopathic compounds released by weeds may interfere with the nutrient uptake mechanisms of pearl millet. This can lead to nutrient deficiencies in the soil, negatively impacting the growth and development of the crop (Qureshi et al. 2024). Allelopathic substances released by weeds can have direct toxic effects on pearl millet. These chemicals may hinder seed germination, root development, and overall plant growth, leading to reduced crop yields (Choudhary et al. 2023). Weed allelopathy can also influence the composition and activity of soil microbial communities. Changes in the soil microbiome may impact nutrient cycling, soil structure, and overall soil health, affecting the growth of pearl millet (Scavo et al. 2019; Blaise et al. 2021; Kotra et al. 2023). Millets face unique challenges when it comes to managing weeds during their early growth stages as they are characterized by their wider row spacing and slower initial growth phase. Therefore, it becomes crucial to implement effective weed control measures early in the growth cycle to maximize crop yields (Ajeesh et al., 2022; Gangaiah and Yadav 2024; Yonli et al. 2024).
Weeds pose a significant threat to agricultural production, resulting in decreased product quality and market value. Weeds engage in fierce competition with crops for essential resources such as water, nutrients, light, and space, ultimately leading to reduced crop yields (Padu et al. 2023). Historically, farmers have relied on chemical herbicides to manage weed growth, but unfortunately, these chemicals have negative effects on soil quality, plants (Kakhki et al. 2022a). Naseri et al. (2018) reported that using herbicide increased the root rot incidence in bean plants. Also, chemical herbicides are toxic to humans causing various health problems (Yates et al. 2024). Additionally, the widespread use of chemical herbicides has led to weed resistance. Hence, there is a growing need to develop alternative strategies like mechanical (hand weed controlling, planting at appropriate date and other agroecological properties (Kakhki et al. 2022b; Naseri and Kakhki 2022; Naseri 2023), choosing resistance cultivars (Naseri and Safaee 2023), and biological methods for effective weed control to ensure sustainable agriculture (Raza et al. 2021).
Biological control methods for weeds have gained significant attention as safe and effective alternatives. Bioherbicides encompass the use of plant extracts or microorganisms such as fungi or bacteria (Verma et al. 2020). Microbial bioherbicides contain microorganisms like bacteria (Fang et al. 2022), fungi (Kakhaki et al. 2017; Todero et al. 2020; Tan et al. 2024), viruses (Charudattan 2024) or protozoa (Marini et al. 2021) as their active components. These bioherbicides have the potential to manage a wide range of weeds, with each active component exhibiting relatively specific activity against its target weeds (Jampílek and Kráľová 2022). The use of soil microorganisms as bioherbicides relies on their ability to detoxify allelochemicals secreted in the soil by weeds. Moreover, these microorganisms can be host-specific, promoting crop plant growth while inhibiting weed growth (Bo et al. 2020; Ramesh and Abinaya 2022; Roberts et al. 2022; Jelena et al. 2023; Charudattan 2024; Tan et al. 2024).
Addressing the issue of weed residue is another crucial aspect to minimize its adverse effects on crop plant growth. Various weed control methods leave behind weed residue in the soil, which can transport allelochemicals to crop plants even in the absence of actively growing weeds (Rogers 2020). Khatri et al. (2023) reported the harmful impact of Ageratina adenophora leaf residues on the production of two rabi crops. Additionally, Padu et al. (2023) discovered that the germination of seeds and nutrient uptake in various crops significantly decreased when exposed to extracts from weed species such as Poa annua, Erigeron annuus, and Stellaria media. Hence, it is equally important to find safe strategies that enhance crop plants’ tolerance to allelochemicals from weed residues (Xiao et al. 2020).
From the perspective of weed residue phytotoxicity, this study aims to assess the impact of priming pearl millet seeds with specific soil microorganisms to alleviate the allelopathic effects of certain weed extracts. The investigation focuses on the effects of seed priming with soil microorganism on pearl millet germination and metabolic status in the presence of weed extracts.
Materials and methods
Preparation of soil microorganisms
We used Bacillus velezensis (ATCC 6051), Pseudomonas fluorescens (ATCC 13,525), Serratia marcescens (ATCC 13,880), and Trichoderma viride (ATCC 28,020) as these soil microorganisms are commonly used as biocontrol agents against different plant diseases. We acquired these strains from the American Type Culture Collection in USA. These microorganisms were cultured following the manufacturer’s guidelines to create a microbial suspension at a concentration of 108 colony-forming units per milliliter (CFU/mL). This microbial suspension served as the biopriming solution.
Preparation of weed residue extracts
We used the most common weeds that can invade the pearl millets cultivated lands. Weed species, including Brachiaria ramose, Cynodon dactylon, Dactyloctenium aegyptium, Digitaria marginata, Paspalum paspaloides, Panicum dichotomiflorum, and Sorghum halepense, were collected the weeds in vegetative stage from various farms in Qilwah, Al-Baha region, Saudi Arabia. The whole plant was (leaves, stems and root system) were thoroughly cleaned, air-dried, and subsequently ground into a fine powder. An extract was prepared for each weed species by mixing 20 g of the weed powder with 100 mL of distilled water, followed by overnight incubation at room temperature with periodic shaking. After incubation, the mixture was filtered through filter paper (Whatman nº1), and the resulting filtrate was stored in dark bottle in the refrigerator at 1 °C for use as the weed extract.
Germination of pearl millet seeds
Pearl millet seeds were obtained from Millborn Seeds. The seeds were subjected to surface sterilization using 70% sodium hypochlorite for 15 min, followed by multiple rinses with sterile distilled water. The seeds were then divided into five groups. The first group underwent hydropriming, while the remaining four groups were bioprimed using the prepared microbial suspension at a concentration of 108 CFU/mL of B. velezensis, P. fluorescens, S. marcescens, and T. viride. Ten seeds of each group were placed in 10 cm-diameter Petri dishes containing a piece of cotton saturated with either one of the prepared weed extracts (20 mL) or water (20 mL) as a control. The experiment included forty experimental groups (Supplementary Table S1). The forty groups were incubated in dark at 30 °C and 40% humidity for a week. After incubation, the germination percentage, radicle, and plumule length were measured, and the seed vigor index was calculated using the formula:
Following this, the entire seedlings were rapidly frozen using liquid nitrogen and stored at -18 °C for subsequent biochemical analysis.
We repeated the experiment three times successively and we collected the samples from each time and stored − 18 °C for subsequent biochemical analysis.
Activity of hydrolysis enzymes during germination
The hydrolysis of stored organic compounds is a critical biochemical process during germination, as it provides the essential simple compounds required for the embryo’s energy during germination (Batool et al. 2022).
Organic Phosphate Hydrolysis: Phytase activity was determined using the K-Phytase kit 09/21 (Megazyme, Wicklow, Ireland). One unit of the enzyme was defined as the enzyme that liberates 1 µmol of phosphate per minute. Phytate content was determined using the K-PHYT Phytic Acid (Phytate)/Total Phosphorus Kit 05/19 (Megazyme, Wicklow, Ireland).
Starch Hydrolysis: Amylase activity was assessed according to the protocol provided by K-CERA 02/22 (Megazyme, Wicklow, Ireland). One unit of enzyme activity was defined as the amount of enzyme that releases 1 µmol of reducing sugar per minute. Total soluble sugar was determined using the phenol-sulfuric acid method (Nielsen 2017).
Oxidative stress markers and antioxidant enzyme activities
Oxidative stress markers
Hydrogen peroxide (H2O2) content was determined using the method described by Alexieva et al. (2001), and lipid peroxidation was assessed by measuring malonyl dialdehyde (MDA) levels as per Li (2000).
Antioxidant enzymes
Crude enzyme extracts were obtained from the germinated seedlings by centrifuging the homogenate of 5 g of germinated seeds in cold phosphate buffer (pH 6.5) containing 1 mM EDTANa2 (Saroop et al. 2002). The activity of antioxidant enzymes was measured in this crude extract. Superoxide dismutase (SOD) activity was determined based on the nitro blue tetrazolium (NBT) reduction method, following the procedure of Beyer (1987). Polyphenol oxidase (PPO) and peroxidase activities were determined by the oxidation of pyrogallol, following the method of Kar and Mishra (1976).
Components of secondary metabolism
Shikimic acid content
The shikimic acid content was determined in germinated seedlings according to Zelya et al. (2011).
Phenylalanine ammonia-lyase
The activity of phenylalanine ammonia-lyase was assessed using the method outlined by Rösler et al. (1997), which involves measuring the formation of cinnamic acid.
Phenols and flavonoids
Total phenols and total flavonoids were extracted from sprouting seedlings, following the methodology outlined by Campbell and Ellis (1992). The quantification of phenolic content was conducted using the Folin-Ciocalteu assay, while the assessment of flavonoid content was carried out using the AlCl3 assay, as described by Pallab et al. (2013).
Statistical analysis
The data from the three experiments were inputted into SPSS (version 14), where the mean and standard deviation were computed for each treatment based on three replicates. The results were presented as mean ± standard deviation (SD). To assess the significance of the differences between treatment groups and the control, paired T-tests were employed. A significance level of p < 0.01 was chosen to determine statistical significance.
Results
Effect of soil microorganisms on pearl millet germination under weed extract treatment
The results indicate that priming with soil microorganisms led to improved germination parameters under weed treatment conditions (Table 1; Fig. 1). Weed treatment significantly reduced the germination percentage of hydroprimed seeds. The lowest germination percentage (46.667%) was observed in hydro-primed seeds affected by B. ramose or P. dichotomiflorum. In contrast, under weed treatments, seeds primed with soil microorganisms exhibited a non-significant decrease in germination percentage compared to the control group. Notably, S. marcescens and T. viride demonstrated the best germination percentage under weed treatment conditions. Under the treatment of Cynodon dactylon, Dactyloctenium aegyptium, and Digitaria marginata, the germination percentage was 93.33% in the S. marcescens-primed seeds and 96.667% in T. viride-primed seeds (Table 1).
Effect of priming with soil microorganisms on plumule and radicle length under different weeds treatments. A seeds germinated on normal conditions (water), B seeds germinated under Brachiaria ramose treatment, C seeds germinated under Cynodon dactylon treatment, D seeds germinated under Dactyloctenium aegyptium treatment, E seeds germinated under Digitaria marginata treatment, F seeds germinated under Paspalum paspaloides treatment, G seeds germinated under Panicum dichotomiflorum treatment, H seeds germinated under Sorghum halepense treatment. Data are means of three replicates. Columns followed by asterisk are significantly different from the control according to paired T test, P < 0.01
Another important parameter in healthy germination is seed vigor, which depends on the seedling length. Soil microorganisms priming significantly improved the radicle and plumule length (Fig. 1) and thus the seed vigor (Table 1) under both normal conditions and weed treatment. Under normal conditions, the highest seed vigor index was 1043.3 in the case of T. viride-primed seeds, while it was 683.1 in the control seeds. Also, under weed treatment, T. viride-primed seeds showed the highest vigor index, 957.0, under the Cynodon dactylonI treatment, while the lowest seed vigor index was recorded, 132.2, in the hydroprimed seeds under Panicum dichotomiflorum treatment (Table 1).
Effect of soil microorganisms on hydrolysis enzymes in germinated pearl millet under weed extract treatment
The phytase enzyme catalyzes the hydrolysis of organic phosphate stored in seeds, and thus, organic phosphate hydrolysis depends on phytase activity. Under weed treatment, organic phosphate hydrolysis significantly decreased in the hydroprimed germinated seeds, as phytase activity notably decreased, leading to a significant accumulation of phytate in the hydroprimed seeds germinated under weed treatment. The lowest phytase activity recorded was 0.50 U/g fresh weight in hydroprimed seeds treated with Panicum dichotomiflorum and Sorghum halepense. On the other hand, priming with soil microorganisms significantly improved organic phosphate hydrolysis by increasing phytase activity, resulting in decreased phytate content under both normal and weed treatment conditions. The phytase activity reached approximately 2.99 U/g fresh weight in T. viride-primed seeds under normal conditions, and this activity decreased to about 2.70 U/g fresh weight under weed treatments (Figs. 2 and 3).
Effect of priming with soil microorganisms on phytase activity in seeds germinated under under different weeds treatments. A seeds germinated on normal conditions (water), B seeds germinated under Brachiaria ramose treatment, C seeds germinated under Cynodon dactylon treatment, D seeds germinated under Dactyloctenium aegyptium treatment, E seeds germinated under Digitaria marginata treatment, F seeds germinated under Paspalum paspaloides treatment, G seeds germinated under Panicum dichotomiflorum treatment, H seeds germinated under Sorghum halepense treatment. Data are means of three replicates. Columns followed by asterisk are significantly different from the control according to paired T test, P < 0.01
Effect of priming with soil microorganisms on phytate content in seeds germinated under under different weeds treatments. A seeds germinated on normal conditions (water), B seeds germinated under Brachiaria ramose treatment, C seeds germinated under Cynodon dactylon treatment, D: seeds germinated under Dactyloctenium aegyptium treatment, E seeds germinated under Digitaria marginata treatment, F seeds germinated under Paspalum paspaloides treatment, G seeds germinated under Panicum dichotomiflorum treatment, H seeds germinated under Sorghum halepense treatment. Data are means of three replicates. Columns followed by asterisk are significantly different from the control according to paired T test, P < 0.01
Table 2 illustrates the changes in amylase activity and soluble sugar content in germinated pearl millet seeds subjected to weed treatment. Amylase is the enzyme that catalyzes the conversion of storage starch to soluble carbohydrates, thus governing carbohydrate hydrolysis in germinated seeds. Under weed treatment, hydroprimed germinated seeds exhibited a significant decrease in carbohydrate hydrolysis, characterized by a significant reduction in both amylase activity and soluble sugar content.
The amylase activity in hydroprimed seeds germinated under normal conditions was 2.40 U/g fresh weight, and this activity dropped to 0.74 U/g fresh weight in hydroprimed seeds under Paspalum paspaloides treatment. In contrast, germinated seeds primed with soil microorganisms displayed notably higher amylase activity than the control group, both under normal conditions and weed treatment. Amylase activity increased from 2.40 U/g fresh weight in hydroprimed seeds under normal conditions (control) to 4.05 U/g fresh weight in T. viride-primed germinated seeds under normal conditions. Under weed conditions, soil microorganisms priming protected amylase activity, ranging from 3.33 to 3.88 U/g fresh weight, which is significantly higher than that of the control. Interestingly, despite the significant increase in amylase activity in soil microorganism-primed seeds compared to the control, there was a non-significant difference observed in soluble sugar content between the control group and the soil microorganism-primed seeds under weed treatment (Table 2).
Effect of soil microorganisms on oxidative stress markers and antioxidant enzyme activities in germinated pearl millet under weed extract treatment
Hydrogen peroxide is one of the reactive oxygen species that can induce peroxidation in various biological macromolecules such as lipids, proteins, and nucleic acids. H2O2 and malonyl dialdehyde (MDA), a product of lipid peroxidation, are recognized as markers of oxidative stress. These oxidative stress markers showed a significant increase in hydroprimed germinated seeds under weed treatment. The H2O2 content escalated in hydroprimed seeds from 1.80 µg/g fresh weight under normal conditions (control) to over 4.00 µg/g fresh weight under weed treatments. Similarly, the MDA content in hydroprimed germinated seeds increased from 0.48 µM/g fresh weight under normal conditions to more than 3.80 µg/g fresh weight under weed treatment. On the other hand, soil microorganism priming demonstrated a significant reduction in the content of oxidative stress markers under normal conditions. Although the oxidative stress markers increased under weed treatment in soil microorganism-primed germinated seeds, their content was not significantly different from that of the control. Under weeds treatment H2O2 content in soil microorganism-primed seeds ranged from 1.62 to 1.76 µg/g fresh weight, which was not significantly different from that of the control (1.80 µg/g fresh weight). Similarly, under weed treatments, MDA content in soil microorganism-primed seeds ranged from 0.35 to 0.44 µM/g fresh weight, which was not significantly different from that of the control (0.48 µM/g fresh weight) (Table 3).
Plants mitigate the oxidative stress through the activity of the antioxidant enzymes. Results in Figs. 4, 5 and 6 show the changes in superoxide dismutase (SOD), peroxidase (POX), and polyphenol oxidase (PPO) activities, respectively, in the hydroprimed and soil microorganisms primed germinated seeds under the different treatments of weeds extract. The priming with soil microorganisms significantly increased the antioxidant enzymes under weed treatments, while the hydroprimed seeds showed non-significant changes in the antioxidant enzymes under weed treatment except for the superoxide dismutase, which showed a significant increase under weed treatments (Fig. 4).
Effect of priming with soil microorganisms on super oxide dismutase (SOD) in seeds germinated under under different weeds treatments. A seeds germinated on normal conditions (water), B seeds germinated under Brachiaria ramose treatment, C: seeds germinated under Cynodon dactylon treatment, D seeds germinated under Dactyloctenium aegyptium treatment, E seeds germinated under Digitaria marginata treatment, F seeds germinated under Paspalum paspaloides treatment, G seeds germinated under Panicum dichotomiflorum treatment, H seeds germinated under Sorghum halepense treatment. Data are means of three replicates. Columns followed by asterisk are significantly different from the control according to paired T test, P < 0.01
Effect of priming with soil microorganisms on peroxidasse (POX) in seeds germinated under under different weeds treatments. A seeds germinated on normal conditions (water), B seeds germinated under Brachiaria ramose treatment, C seeds germinated under Cynodon dactylon treatment, D seeds germinated under Dactyloctenium aegyptium treatment, E seeds germinated under Digitaria marginata treatment, F seeds germinated under Paspalum paspaloides treatment, G seeds germinated under Panicum dichotomiflorum treatment, H seeds germinated under Sorghum halepense treatment. Data are means of three replicates. Columns followed by asterisk are significantly different from the control according to paired T test, P < 0.01
Effect of priming with soil microorganisms on polyphenol oxidase (PPO) in seeds germinated under under different weeds treatments. A seeds germinated on normal conditions (water), B seeds germinated under Brachiaria ramose treatment, C seeds germinated under Cynodon dactylon treatment, D seeds germinated under Dactyloctenium aegyptium treatment, E seeds germinated under Digitaria marginata treatment, F seeds germinated under Paspalum paspaloides treatment, G seeds germinated under Panicum dichotomiflorum treatment, H seeds germinated under Sorghum halepense treatment. Data are means of three replicates. Columns followed by asterisk are significantly different from the control according to paired T test, P < 0.01
Change in secondary metabolism components
Under various stress conditions, plant cells induce secondary metabolic pathways to produce compounds that aid in stress resistance. Shikimic acid and phenylalanine ammonia-lyase (PAL) are considered pivotal in various secondary metabolic pathways. Figures 7 and 8 present the changes in shikimic acid content and PAL activity in the different studied groups, respectively. In the case of shikimic acid, soil microorganisms priming significantly reduced the content to 3.03 µg/g fresh weight in the control, dropping below unity under normal conditions or weed treatment. Conversely, hydroprimed germinated seeds showed a significant increase in shikimic acid content under weed treatment (Fig. 7). Phenylalanine ammonia-lyase, acting as the gateway to secondary metabolism, exhibited significantly higher activity in seeds primed with soil microorganisms under weed treatments, while its activity remained unchanged in hydroprimed seeds under weed treatments (Fig. 8).
Effect of priming with soil microorganisms on shikimic acid in seeds germinated under under different weeds treatments. A seeds germinated on normal conditions (water), B seeds germinated under Brachiaria ramose treatment, C seeds germinated under Cynodon dactylon treatment, D seeds germinated under Dactyloctenium aegyptium treatment, E seeds germinated under Digitaria marginata treatment, F seeds germinated under Paspalum paspaloides treatment, G seeds germinated under Panicum dichotomiflorum treatment, H seeds germinated under Sorghum halepense treatment. Data are means of three replicates. Columns followed by asterisk are significantly different from the control according to paired T test, P < 0.01
Effect of priming with soil microorganisms on phenyl alanine ammonia lyase (PAL) in seeds germinated under under different weeds treatments. A seeds germinated on normal conditions (water), B seeds germinated under Brachiaria ramose treatment, C seeds germinated under Cynodon dactylon treatment, D seeds germinated under Dactyloctenium aegyptium treatment, E seeds germinated under Digitaria marginata treatment, F seeds germinated under Paspalum paspaloides treatment, G seeds germinated under Panicum dichotomiflorum treatment, H seeds germinated under Sorghum halepense treatment. Data are means of three replicates. Columns followed by asterisk are significantly different from the control according to paired T test, P < 0.01
Phenols and flavonoids represent the primary secondary metabolites. Under weed treatment, soil microorganisms significantly increased total phenols and total flavonoids. Phenol content rose from 15.42 mg/g fresh weight in the control to over 42.00 mg/g fresh weight in soil microorganisms-primed germinated seeds under weed treatment. Flavonoid content increased from 48.90 µg/g fresh weight in the control to over 115.00 µg/g fresh weight in soil microorganisms-primed germinated seeds under weed treatment. Conversely, hydroprimed germinated seeds under weed treatment showed non-significant changes in total phenols and total flavonoids compared to the control (Table 4).
Discussion
Soil microorganisms are very effective in improving plant growth from germination to fruiting, besides their positive role in improving plant tolerance against different stress conditions (Ramandi and Seifi 2023). Seed biopriming with rhizosphere plant growth-promoting microorganisms is a well-reported technique for introducing soil microorganisms to improve plant germination and growth under different stress conditions (Mitra et al. 2021). Our results showed that seed priming with soil microorganisms improved pearl millet germination under weed extract treatments that significantly reduced the germination percent, plumule length, radicle length, and seed vigor in the hydroprimed seeds. The reduction of germination through the allelopathic effect of the weeds can be explained through the inhibition of nutrient uptake through the reduction in gibberellin content, which negatively affects the hydrolysis enzyme activity, which supplies the embryo with simple nutrients needed for energy production for healthy germination (Choudhary et al. 2023). Zareen et al. (2022) reported the allopathic effect of weeds on the germination of chickpeas and wheat due to the role of the allelochemicals in the availability of nutrients. Similarly, Padu et al. (2023) reported the inhibitory effect of the weeds on the germination of Hordeum vulgare, Brassica juncea, Triticum aestivum, and Eleusine coracana due to the effect of the allelochemicals. Casuarina equisetifolia-L leaf aquatic extract negatively affected the seed germination and growth of wheat, maize, mustard, and lentils (Ahmed et al. 2019). This allelopathic effect of C. equisetifolia is related to 2,4-di-tert-butylphenol (2,4-DTBP), which is the major allelochemical of the C. equisetifolia litter exudates (Xu et al. 2022).
The present work shows that priming with soil microorganisms improved the germination under the weeds treatments, this in the same line with what is reported that the soil microorganisms can mitigate the effect of the weeds; thus, they are a candidate for safe bioherbicide production (Neto et al. 2021). Similarly, de Matos et al. (2019) reported that soil microorganisms improved the interaction between maize and weeds, and maize growth increased with the improvement in soil microorganism activity. Also, Raza et al. (2021) reported the effectiveness of the rhizobacteria in biocontrolling the weeds in wheat agriculture. Soil microorganisms can induce germination under weed treatments by detoxifying allelochemicals. This process aids seeds in germinating without being adversely affected by the toxic impact of the weeds. Alternatively, they can stimulate the production of growth hormones such as gibberellins, which activate hydrolytic enzymes, promoting a healthier germination process (Makhaye et al. 2021; Xiao et al. 2020).
The hydrolysis process during seed germination is the key to all metabolic pathways in the germinated seeds (Nautiyal et al. 2023). Carbohydrates and phytate are the main storage materials in cereal seeds such as rice, wheat, and pearl millet (Samtiya et al. 2020; Hassan et al. 2021). The hydrolysis of these storage materials is the source of energy for various metabolic activities during germination. Additionally, they serve as a reservoir of building blocks for other essential components required for seedling growth and resistance against adverse conditions (Batool et al. 2022). The different stress conditions mainly affect seed germination by disturbing the hydrolysis processes (El Moukhtari et al. 2023). The weed residue in the soil is one of the environmental stresses that can inhibit the germination of the crop seeds by deactivating the hydrolysis process (de Souza Coelho et al. 2022). Similarly, the weed extract in the present study significantly reduced the carbohydrate and phytate hydrolysis by affecting the amylase and phytase activity. This inhibition is related to the toxic allelochemicals in the weed extract (Zareen et al. 2022). Seed priming can mitigate the adverse effects of different environmental stresses on seed germination (Rasheed et al. 2022). Priming the pearl millet seeds with soil microorganisms significantly improved the phytate and carbohydrate hydrolysis under weed treatments. Improving carbohydrate and organic phosphate hydrolysis and their immobilization during germination helps the seeds germinate under stress conditions (Wang et al. 2022). Similarly, Ghannad et al. (2022) reported that the activation of hydrolytic enzymes improved the germination of Dracocephalum kotschyi dormant seeds. Trichoderma biopriming increased the germination of soya beans through the activation of hydrolysis enzymes and nutrient mobilization (Paul and Rakshit 2023). Soil microorganisms priming increased the hydrolysis enzymes activity is related to the enhancement of its catalytic properties, and increasing its affinity to the substrate makes it more resistant to the differences in the surrounding conditions under stress (Al-Hazmi and Naguib 2022; Al Hijab et al. 2024). In addition, priming with soil microorganisms induces gibberellin synthesis, which is the main phytohormone responsible for the activation of the hydrolysis enzymes during seed germination (Singh et al. 2018; Makhaye et al. 2021).
Production of reactive oxygen species (ROS) under stress conditions is a well-documented metabolic reaction that induces oxidative stress if there is not sufficient antioxidant machinery to antagonize the harmful effect of these excess reactive oxygen species. The excess of these ROS attacks the large molecules of the cells, such as lipids, proteins, and nucleic acids, causing their denaturation and deactivation. Lipid peroxidation is one of the most common markers of oxidative stress (Kumar et al. 2021). Weed treatments significantly increased the oxidative stress markers, hydrogen peroxide, and lipid peroxidation, in the hydroprimed seeds, while in the seeds primed with soil microorganisms, there was no significant change in the oxidative stress markers. Šoln et al. (2022) reported that allelochemicals from weeds cause a burst of ROS in the plant cells, which results in oxidative stress and then cell death. The seed biopriming with soil microorganisms mitigates the toxic effect of the excess ROS and prevents oxidative stress by improving the antioxidant enzyme activity, which detoxifies the excess ROS (Mitra et al. 2021). Pérez-García et al. (2023) reported the ability of the seed biopriming with soil microorganisms to up-regulate the antioxidant enzymes in seedlings, which ceases the negative effect of the ROS. Similarly, the present results showed that the pearl millet priming with soil microorganisms significantly increased the activity of the antioxidant enzymes that save the oxidative stress marker content, similar to the control, which means the mitigation of the oxidative stress induced by the weed treatments. Also, Haroon et al. (2022) reported the efficiency of soil microorganism priming in mitigating oxidative stress in wheat seeds germinated under stress. The positive role of the soil microorganisms in activation the antioxidant enzymes under stress is well reported as soil microorganisms help in induction defense genes which activates the antioxidant enzymes (Pérez-García et al. 2023). Beside soil microorganisms priming improve the kinetics parameters of the antioxidant enzymes (Al Hijab et al. 2024).
Secondary metabolism is a specialized metabolic pathway that produces specialized compounds that help plants adapt to different environmental conditions (Rajčević et al. 2023). These secondary metabolites have a significant role in the defense mechanism and tolerance against different stress conditions, improving plant growth and yield. The secondary metabolites include many different compounds found in small amounts under normal conditions, but their content increases according to the plant’s needs under different stress conditions. Thus, the induction of secondary metabolism under different stress conditions is a common strategy in tolerant plant species (Chakraborty 2022). Shikimic acid is an important precursor for many secondary metabolite syntheses (Jha and Mohamed 2022). Its accumulation in plant tissues is an indicator of impairment in the secondary metabolism pathways (Guo et al. 2021). The pearl millet seeds primed with soil microorganisms showed a significant decrease in the shikimic acid content under weed treatments, while the hydroprimed seeds showed accumulation in the shikimic acid content under weed treatments. The accumulation of the shikimic acids is an indicator of the sensitivity to stress conditions, as the tolerant species can consume the shikimic acid to synthesize the secondary metabolites used in the defense mechanism (Malalgoda et al. 2020; Sweellum and Naguib 2023). Another important component in the secondary metabolism pathways is Phenylalanine ammonia-lyase (PAL). PAL is a key enzyme for the gate of secondary metabolism in plants. PAL shares in the phenylpropanoids synthesis such as phenols and flavonoids. The activity of PAL is very important for plant growth under stress (Barros and Dixon 2020). The soil microorganism priming significantly increased the PAL in pearl millet germinated seeds under weed treatments, while for the other hydroprimed seeds, the increase was non-significant compared to the control. Similarly, Qin et al. (2022) reported that the stress-tolerant plants have higher PAL activity than the sensitive ones. The increase in PAL expression and activity increased the seed vigor index and germination under different stress conditions (Zhang et al. 2022). Plant growth-promoting microorganisms share in the induction and activation of phenylalanine ammonia-lyase to increase the plant’s tolerance to different external stimuli (Sarraf et al. 2023). The activity of PAL is a major point in the formation of phenols and flavonoids, which participate in the plant’s tolerance against different stresses (Tak et al. 2023). Liu et al. (2023) reported that the high PAL transcription and activity in Euryale ferox resulted in high polyphenol and flavonoid content. Similarly, the present results show that the significant increase in PAL activity is accompanied by a significant increase in phenols and flavonoid content in pearl millet seeds primed with the soil microorganisms germinated under weed treatments. This is in line with reports by Lourenzi et al. (2022) that soil plant growth-promoting microorganisms can induce the synthesis of secondary metabolites such as phenols and flavonoids in plants under the allelopathic effect of different weeds. Also, Pérez-García et al. (2023) reported that rhizobacteria priming can improve the seed vigor index and germination under stress conditions through the activation of the synthesis of bioactive compounds such as phenols and flavonoids. Phenols and flavonoids are widespread secondary metabolites that have an important role in plant tolerance against different stresses. They act as non-enzymatic antioxidants, which mitigate oxidative stress (Kaur et al. 2023; Mishra et al. 2023). Shikimate and Phenylalanine ammonia-lyase play a pivotal role in phenol and other secondary metabolite biosynthesis, bridging primary metabolism with secondary metabolism (Tak et al. 2023). This bridging is very clear in the present study, as in the pearl millet seeds primed with soil microorganisms; however, the amylase activity increased significantly and the soluble sugar content remained with a non-significant change than that of the control. This is in line with Wei et al. (2023), who reported that starch metabolism and phenylpropanoid biosynthesis are involved in defense responses to stress.
Seed biopriming with soil microorganisms can mitigate the toxic effects of weed on pearl millet growth. This provide insights into sustainable agricultural practices, reducing reliance on synthetic chemicals, promoting beneficial microbial communities, integrating biological control, aligning with agroecological principles, and addressing food security challenges in specific agroecosystems. This knowledge contributes to a more holistic and environmentally friendly approach to weed management, supporting the long-term sustainability of agricultural systems.
Conclusion
Biopriming pearl millet seeds with specific soil microorganisms significantly enhanced germination under various weed extract treatments by optimizing seed metabolism, increasing antioxidant enzymes, and improving the hydrolysis process. This approach not only alleviated oxidative stress induced by weeds but also conserved energy for primary metabolism, enabling resources to be redirected to secondary metabolism for the formation of defense molecules. This knowledge supports a holistic and environmentally friendly weed management approach, contributing to the long-term sustainability of agricultural systems.
Data availability
All data generated or analyzed during this study are included in this published article and its supplementary file.
References
Ahmed TA, Abou Elezz A, Al-Sayed NH (2019) Dataset of allelopathic effects of Casuarina equisetifolia-L leaf aquatic extract on seed germination and growth of selected plant crops. Data Brief 27:104770. https://doi.org/10.1016/j.dib.2019.104770
Ajeesh KTP, Maharajan T, Ceasar SA (2022) Improvement of millets in the post-genomic era. Physiol Mol Biol Plants 28:669–685. https://doi.org/10.1007/s12298-022-01158-8
Al Hijab LYA, Al-Hazmi NE, Naguib DM (2024) Rhizobacteria-priming improves common bean seeds germination under different abiotic stresses through improving hydrolysis and antioxidant enzymes kinetics parameters. Rhizosphere 29:100842. https://doi.org/10.1016/j.rhisph.2023.100842
Al-Hazmi NE, Naguib DM (2022) Amylase properties and its metal tolerance during rice germination improved by priming with rhizobacteria. Rhizosphere 22:100518. https://doi.org/10.1016/j.rhisph.2022.100518
Alexieva V, Sergio I, Mapelli S, Karanov E (2001) The effect of drought and ultraviolet radiation on growth and stress markers in pea and wheat. Plant Cell Environ 24:1337–1344. https://doi.org/10.1046/j.1365-3040.2001.00778.x
Barros J, Dixon RA (2020) Plant phenylalanine/tyrosine ammonia-lyases. Trends Plant Sci 25:66–79. https://doi.org/10.1016/j.tplants.2019.09.011
Batool M, El-Badri AM, Wang C, Mohamed IAA, Wang Z, Khatab A, Bashir F, Xu Z, Wang J, Kuai J, Wang B, Zhou G (2022) The role of storage reserves and their mobilization during seed germination under drought stress conditions of rapeseed cultivars with high and low oil contents. Crop Environ 1(4):231–240. https://doi.org/10.1016/j.crope.2022.09.003
Beyer WF Jr (1987) Assaying for superoxide dismutase activity: some large consequences of minor changes in conditions. Anal Biochem 161:559–566. https://doi.org/10.1016/0003-2697(87)90489-1
Blaise D, Velmourougane K, Santosh S, Manikandan A (2021) Intercrop mulch affects soil biology and microbial diversity in rainfed transgenic bt cotton hybrids. Sci Total Environ 794:148787. https://doi.org/10.1016/j.scitotenv.2021.148787
Bo AB, Khaitov B, Umurzokov M, Cho KM, Park KW, Choi JS (2020) Biological control using plant pathogens in weed management. Weed Turfgrass Sci 9:11–19. https://doi.org/10.5660/WTS.2020.9.1.11
Campbell MM, Ellis BE (1992) Fungal elicitor-mediated responses in pine cell cultures. Planta 186:409–417. https://doi.org/10.1007/BF00195322
Chakraborty R (2022) Role of secondary metabolites and prospects of engineering secondary metabolite production for crop improvement. In: Roy S, Mathur P, Chakraborty AP, Saha SP (eds) Plant stress: challenges and management in the new decade. advances in science, technology & innovation. Springer, Cham, pp 401–419. https://doi.org/10.1007/978-3-030-95365-2_25
Charudattan R (2024) Use of plant viruses as bioherbicides: the first virus-based bioherbicide and future opportunities. Pest Manag Sci 80:103–114. https://doi.org/10.1002/ps.7760
Chinyo M, Raj S, Manjesh G (2023) Weed management with pre- and post-emergence herbicide in rainfed pearl millet under conservation agriculture. Ind J Weed Sci 55:223–227. https://doi.org/10.5958/0974-8164.2023.00041.2
Choudhary CS, Behera B, Raza MB, Mrunalini K, Bhoi TK, Lal MK, Nongmaithem D, Pradhan S, Song B, Das TK (2023) Mechanisms of allelopathic interactions for sustainable weed management. Rhizosphere 25:100667. https://doi.org/10.1016/j.rhisph.2023.100667
de Matos CC, Monteiro LCP, Gallo SAD, Costa MD, da Silva AA (2019) Changes in soil microbial communities modulate interactions between maize and weeds. Plant Soil 440:249–264. https://doi.org/10.1007/s11104-019-04066-1
de Souza Coelho LC, Mignoni DSB, Barbedo CJ (2022) Braga MR (2022) seed leachates of the tropical legume Sesbania virgata: their effects on germination and seedling growth of tomato and rice. Acta Physiol Plant 44:96. https://doi.org/10.1007/s11738-022-03431-5
El Moukhtari A, Ksiaa M, Zorrig W, Cabassa C, Abdelly C, Farissi M, Savoure A (2023) How silicon alleviates the effect of abiotic stresses during seed germination: a review. J Plant Growth Regul 42:3323–3341. https://doi.org/10.1007/s00344-022-10794-z
Fang W, Liu F, Wu Z, Zhang Z, Wang K (2022) Plant-associated bacteria as sources for the development of Bioherbicides. Plants 11(23):3404. https://doi.org/10.3390/plants11233404
Gangaiah B, Yadav AK (2024) Modern crop management practices for pearl millet cultivation in Asia. In: Tonapi VA, Thirunavukkarasu N, Gupta S, Gangashetty PI, Yadav O (eds) Pearl millet in the 21st Century. Springer, Singapore. https://doi.org/10.1007/978-981-99-5890-0_18
Ghannad R, Haghjou MM, Raza A, Hasanuzzaman M (2022) Induction of hydrolytic enzyme activities in dormant seeds of Dracocephalum Kotschyi Boiss. Causes improvement of germination and seedling vigor indices. Acta Physiol Plant 44:48. https://doi.org/10.1007/s11738-022-03381-y
Guo H, Lyv Y, Zheng W, Yang C, Li Y, Wang X, Chen R, Wang C, Luo J, Qu L (2021) Comparative Metabolomics reveals two metabolic modules affecting seed germination in Rice (Oryza sativa). Metabolites 11(12):880. https://doi.org/10.3390/metabo11120880
Haroon U, Khizar M, Liaquat F, Ali M, Akbar M, Tahir K, Batool SS, Kamal A, Chaudhary HJ, Munis MFH (2022) Halotolerant plant growth-promoting Rhizobacteria induce salinity tolerance in wheat by enhancing the expression of SOS genes. J Plant Growth Regul 41:2435–2448. https://doi.org/10.1007/s00344-021-10457-5
Hassan ZM, Sebola NA, Mabelebele M (2021) The nutritional use of millet grain for food and feed: a review. Agric Food Secur 10:16. https://doi.org/10.1186/s40066-020-00282-6
Jampílek J, Kráľová K (2022) Chap. 10 - Biopesticides for management of arthropod pests and weeds. In: Rakshit A, Meena VS, Abhilash PC, Sarma BK, Singh HB, Fraceto L, Parihar M, Singh AK. Advances in Bio-inoculant Science, Biopesticides. Woodhead Publishing. pp 133–158. https://doi.org/10.1016/B978-0-12-823355-9.00009-2
Jelena GP, Mile S, Stefan G, Ljubica ST (2023) Weed biological control with fungi-based bioherbicides. Acta Agric Serbica 28:23–37. https://doi.org/10.5937/AASer2355023G
Jha Y, Mohamed HI (2022) Plant secondary metabolites as a tool to investigate biotic stress tolerance in plants: a review. Gesunde Pflanzen 74:771–790. https://doi.org/10.1007/s10343-022-00669-4
Kakhaki SHN, Montazeri M, Naseri B (2017) Biocontrol of broomrape using Fusarium oxysporum f. sp. orthoceras in tomato crops under field conditions. Biocontrol Sci Tech 27(12):1435–1444. https://doi.org/10.1080/09583157.2017.1409338
Kakhki SHN, Moini MR, Naseri B (2022a) Forecasting bean yield losses under weed and fusarium impacts from field plot statistical modeling. Rhizosphere 21:100461. https://doi.org/10.1016/j.rhisph.2021.10046
Kakhki SHN, Taghaddosi MV, Moini MR, Naseri B (2022b) How predict bean production according to complex interactions between bean growth, fusarium and rhizoctonia root rots, fly and weed development under different planting dates and weed control treatments? Heliyon 8(11):e11322. https://doi.org/10.1016/j.heliyon.2022.e11322
Kar M, Mishra D (1976) Catalase, peroxidase, and polyphenol oxidase activities during rice leaf senescence. Plant Physiol 57:315–319. https://doi.org/10.1104/pp.57.2.315
Kaur M, Tak Y, Bhatia S, Kaur H (2023) Phenolics biosynthesis, targets, and Signaling pathways in ameliorating oxidative stress in plants. In: Lone R, Khan S, Mohammed Al-Sadi A (eds) Plant phenolics in abiotic stress Management. Springer, Singapore, pp 149–171. https://doi.org/10.1007/978-981-19-6426-8_8
Khatri K, Bargali K, Bargali SS, Negi B (2023) Effects of leaf residues from Ageratina adenophora on germination, growth and productivity of two rabi crops. Acta Ecol Sinica 43(2):363–374. https://doi.org/10.1016/j.chnaes.2022.05.001
Kotra V, Singh M, Kumar C, Pandey S (2023) Deciphering the role and diversity of microbes present in millet rhizosphere. In: Pudake RN, Kumari M, Sapkal DR, Sharma AK (eds) Millet rhizosphere. rhizosphere biology. Springer, Singapore. https://doi.org/10.1007/978-981-99-2166-9_8
Kumar SPJ, Chintagunta AD, Reddy YM, Rajjou L, Garlapati VK, Agarwal DK, Prasad SR, Simal-Gandara J (2021) Implications of reactive oxygen and nitrogen species in seed physiology for sustainable crop productivity under changing climate conditions. Curr Plant Biol 26:100197. https://doi.org/10.1016/j.cpb.2021.100197
Li HS (2000) Principles and techniques of plant physiological biochemical experiment, 2nd edn. Higher Education Press, Beijing, pp 260–263
Liu A, Wang Y, Wang T, Zhu Y, Wu P, Li L (2023) Comparative metabolomic profiling of secondary metabolites in different tissues of Euryale ferox and functional characterization of phenylalanine ammonia-lyase. Ind Crops Prods 195:116450. https://doi.org/10.1016/j.indcrop.2023.116450
Lourenzi CR, Loss A, Souza M, Comin JJ, Lovato PE, Soares CRFS (2022) The role of PGPR secondary metabolites in alleviating Allelopathic effects (biotic stress) and induced tolerance in plants. In: Sayyed RZ, Uarrota VG (eds) Secondary metabolites and volatiles of PGPR in plant-growth promotion. Springer, Cham. https://doi.org/10.1007/978-3-031-07559-9_8
Makhaye G, Mofokeng MM, Tesfay S, Aremu AO, Staden JV, Amoo SO (2021) Chap. 5 - Influence of plant biostimulant application on seed germination. In: Gupta S, Staden JV (eds) Biostimulants for crops from seed germination to plant development. Academic, pp 109–135. https://doi.org/10.1016/B978-0-12-823048-0.00014-9
Malalgoda M, Ohm JB, Howatt KA, Green A, Simsek S (2020) Effects of pre-harvest glyphosate use on protein composition and shikimic acid accumulation in spring wheat. Food Chem 332:127422. https://doi.org/10.1016/j.foodchem.2020.127422
Marini F, Weyl P, Vidović B, Petanović R, Littlefield J, Simoni S, de Lillo E, Cristofaro M, Smith L (2021) Eriophyid mites in classical Biological control of weeds: Progress and challenges. Insects 12(6):513. https://doi.org/10.3390/insects12060513
Mishra UN, Dey P, Singhal RK, Sahu C, Jena D, Nanda SP, Chauhan J (2023) Plant phenolics: as antioxidants and potent compounds under multiple stresses. In: Lone R, Khan S, Mohammed Al-Sadi A (eds) Plant phenolics in abiotic stress management. Springer, Singapore. https://doi.org/10.1007/978-981-19-6426-8_11
Mitra D, Mondal R, Khoshru B, Shadangi S, Mohapatra PKD, Panneerselvam P (2021) Rhizobacteria mediated seed bio-priming triggers the resistance and plant growth for sustainable crop production. Curr Res Micro Sci 2:100071. https://doi.org/10.1016/j.crmicr.2021.100071
Naseri B (2023) Chap. 5 - The potential of agroecological properties in fulfilling the promise of organic farming: a case study of bean root rots and yields in Iran. In: Sarathchandran UMR, Thomas S, Meena DK (eds) Woodhead Publishing Series in Food Science, Technology and Nutrition, Organic Farming, 2nd edn. Woodhead Publishing, pp 203–236. https://doi.org/10.1016/B978-0-323-99145-2.00011-2
Naseri B, Kakhki SHN (2022) Predicting common bean (Phaseolus vulgaris) productivity according to Rhizoctonia root and stem rot and weed development at field plot scale. Front Plant Sci 13:1038538. https://doi.org/10.3389/fpls.2022.1038538
Naseri B, Safaee D (2023) Rust weather & wheat yield yellow rust, wheat cultivar, and weather conditions are influencing crop yield. World J Environ Biosci 12(3):20–26. https://doi.org/10.51847/hbgyThRY85
Naseri B, Veisi M, Khaledi N (2018) Towards a better understanding of agronomic and soil basis for possible charcoal root rot control and production improvement in bean. Archi Phytopathol Plant Prot 51(7–8):349–358. https://doi.org/10.1080/03235408.2018.1481721
Nautiyal PC, Sivasubramaniam K, Dadlani M (2023) Seed dormancy and regulation of germination. In: Dadlani M, Yadava DK (eds) Seed science and technology. Springer, Singapore, pp 39–66. https://doi.org/10.1007/978-981-19-5888-5_3
Neto JRC, dos Santos MSN, Mazutti MA, Zabot GL, Tres MV (2021) Phoma Dimorpha phytotoxic activity potentialization for bioherbicide production. Biocat Agric Biotech 33:101986. https://doi.org/10.1016/j.bcab.2021.101986
Nielsen SS (2017) Total carbohydrate by phenol-sulfuric acid method. Food Analysis Laboratory Manual. Springer, Cham. https://doi.org/10.1007/978-3-319-44127-6_14
Padu K, Khanduri VP, Singh B, Rawat D, Riyal MK, Kumar KS (2023) Phytotoxicity of common weeds on germination, seedling growth, NPK uptake and chlorophyll content of four hill crops of Garhwal Himalaya. J Agric Food Res 12:100539. https://doi.org/10.1016/j.jafr.2023.100539
Pallab K, Tapan BK, Tapas KP, Ramen K (2013) Estimation of total flavonoids content (TPC) and antioxidant activities of methanolic whole plant extract of Biophytum Sensitivum Linn. J Drug Deliv Therapeut 3:33–37. https://doi.org/10.22270/jddt.v3i4.546
Pandey A, Bolia NB (2023) Millet value chain revolution for sustainability: A proposal for India. Socio-Econ Plan Sci 2023:101592. https://doi.org/10.1016/j.seps.2023.101592
Paul S, Rakshit A (2023) Bio-priming with trichoderma enhanced faster reserve mobilization in germinating soybean cotyledons under graded macronutrients. J Plant Growth Regul 42:5461–5475. https://doi.org/10.1007/s00344-023-10929-w
Pérez-García L-A, Sáenz-Mata J, Fortis-Hernández M, Navarro-Muñoz CE, Palacio-Rodríguez R, Preciado-Rangel P (2023) Plant-growth-promoting rhizobacteria improve germination and bioactive compounds in cucumber seedlings. Agronomy 13(2):315. https://doi.org/10.3390/agronomy13020315
Qin Y, Li Q, An Q, Li D, Huang S, Zhao Y, Chen W, Zhou J, Liao H (2022) A phenylalanine ammonia-lyase from Fritillaria unibracteata promotes drought tolerance by regulating lignin biosynthesis and SA signaling pathway. Inter J Biol Macromol 213:574–588. https://doi.org/10.1016/j.ijbiomac.2022.05.161
Qureshi JA, Abbas A, Salam IU, Bashir F, Siddiqui MF, Dias DA, El-Keblawy A, El-Sheikh MA, Abideen Z (2024) Assessing the effects of Pennisetum glaucum on the soil properties, growth, nutritive, and physiological aspects of the edible pulse crop (Vigna radiata L. Wilczek). J Plant Nutr 47:363–375. https://doi.org/10.1080/01904167.2023.2277392
Rajčević N, Bukvički D, Stojković D, Soković M (2023) Biochemistry of secondary metabolism in plants. In: Carocho M, Heleno SA, Barros L (eds) Natural secondary metabolites. Springer, Cham. https://doi.org/10.1007/978-3-031-18587-8_2
Ramandi A, Seifi A (2023) Suppressive soil microbiota inhibit wilting diseases and enhance growth in sesame. Rhizosphere 25:100668. https://doi.org/10.1016/j.rhisph.2023.100668
Ramesh M, Abinaya S (2022) Chap. 12 - Synergistic effect of biosurfactant with bioherbicides and their effectiveness in the management of weeds. In: Adetunji ICO (eds) Applications of Biosurfactant in Agriculture. Academic Press. pp 227–244. https://doi.org/10.1016/B978-0-12-822921-7.00005-2
Rasheed R, Ashraf MA, Hussain I, Ali S, Riaz M, Iqbal M, Farooq U, Qureshi FF (2022) Priming effect in developing abiotic stress tolerance in cereals through metabolome reprograming. In: Roychoudhury A, Aftab T, Acharya K (eds) Omics approach to manage abiotic stress in cereals. Springer, Singapore, pp 47–71. https://doi.org/10.1007/978-981-19-0140-9_4
Raza T, Khan MY, Nadeem SM, Imran S, Qureshi KN, Mushtaq MN, Sohaib M, Schmalenberger A, Eash NS (2021) Biological management of selected weeds of wheat through co-application of allelopathic rhizobacteria and sorghum extract. Biol Control 164:104775. https://doi.org/10.1016/j.biocontrol.2021.104775
Roberts J, Florentine S, Fernando WGD, Tennakoon KU (2022) Achievements, developments and future challenges in the field of bioherbicides for weed control: a global review. Plants 11(17):2242. https://doi.org/10.3390/plants11172242
Rogers G (2020) Desert Conservation and Management: Biodiversity Threats From Invasive Weeds. In: Goldstein M, DellaSala DA (eds) Encyclopedia of the World’s Biomes. Elsevier, pp 213–221. https://doi.org/10.1016/B978-0-12-409548-9.11796-8
Rösler J, Krekel F, Amrhein N, Schmid J (1997) Maize phenylalanine ammonia-lyase has tyrosine ammonia-lyase activity. Plant Physiol 113:175–179. https://doi.org/10.1104/pp.113.1.175
Samota SR, Singh SP, Hansraj S, Ranjeet S, Godara AS (2022) Effect of weeds control measures on weeds and yield of pearl millet [Pennisetum glaucum L]. Ind J Weed Sci 54:95–97. https://doi.org/10.5958/0974-8164.2022.00017.X
Samtiya M, Aluko RE, Dhewa T (2020) Plant food anti-nutritional factors and their reduction strategies: an overview. Food Prod Process Nutr 2:6. https://doi.org/10.1186/s43014-020-0020-5
Saroop S, Chanda SV, Singh YD (2002) Changes in soluble and ionically bound peroxidase activities during Brassica juncea seed development. Bulg J Plant Physiol 28:26–34
Sarraf M, Janeeshma E, Arif N, Farooqi MQU, Kumar V, Ansari NA, Ghani MI, Ahanger MA, Hasanuzzaman M (2023) Understanding the role of beneficial elements in developing plant stress resilience: signalling and crosstalk with phytohormones and microbes. Plant Stress 10:100224. https://doi.org/10.1016/j.stress.2023.100224
Scavo A, Abbate C, Mauromicale G (2019) Plant allelochemicals: agronomic, nutritional and ecological relevance in the soil system. Plant Soil 442:23–48. https://doi.org/10.1007/s11104-019-04190-y
Singh V, Maharshi A, Singh DP, Upadhyay RS, Sarma BK, Singh HB (2018) Role of microbial seed priming and microbial phytohormone in modulating growth promotion and defense responses in plants. In: Rakshit A, Singh H (eds) Advances in seed priming. Springer, Singapore, pp 115–126. https://doi.org/10.1007/978-981-13-0032-5_8
Singhal T, Satyavathi CT, Singh SP, Mallik M, Sankar SM, Bharadwaj C (2022) Mapping and identification of quantitative trait loci controlling test weight and seed yield of pearl millet in multi agro-climatic zones of India. Field Crops Res 288:108701. https://doi.org/10.1016/j.fcr.2022.108701
Šoln K, Klemenčič M, Koce JD (2022) Plant cell responses to allelopathy: from oxidative stress to programmed cell death. Protoplasma 259:1111–1124. https://doi.org/10.1007/s00709-021-01729-8
Sweellum TA, Naguib DM (2023) Tomato potato onion intercropping induces tomato resistance against soil-borne pathogen, Fusarium oxysporum through improvement soil enzymatic status, and the metabolic status of tomato root and shoot. J Plant Dis Prot 130:245–261. https://doi.org/10.1007/s41348-022-00699-0
Tak Y, Kaur M, Gautam C, Kumar R, Tilgam J, Natta S (2023) Phenolic biosynthesis and metabolic pathways to alleviate stresses in plants. In: Lone R, Khan S, Mohammed Al-Sadi A (eds) Plant phenolics in abiotic stress management. Springer, Singapore, pp 63–87. https://doi.org/10.1007/978-981-19-6426-8_4
Tan M, Ding Y, Bourdôt GW, Qiang S (2024) Evaluation of Bipolaris Yamadae as a bioherbicidal agent against grass weeds in arable crops. Pest Manag Sci 80:166–175. https://doi.org/10.1002/ps.7630
Todero I, Confortin TC, Luft L, Seibel J, Kuhn RC, Tres MV, Zabot GL, Mazutti MA (2020) Concentration of exopolysaccharides produced by Fusarium fujikuroi and application of bioproduct as an effective bioherbicide. Environ Tech 41:2742–2749. https://doi.org/10.1080/09593330.2019.1580775
Vambe MM, Coopoosamy RM, Arthur G, Naidoo K (2023) Potential role of vermicompost and its extracts in alleviating climatic impacts on crop production. J Agric Food Res 12:100585. https://doi.org/10.1016/j.jafr.2023.100585
Verma D, Banjo T, Chawan M, Teli N, Gavankar R (2020) Chap. 10 - Microbial Control of Pests and Weeds. In: Egbuna C, Sawicka B (eds) Natural Remedies for Pest, Disease and Weed Control. Academic Press, pp119–126. https://doi.org/10.1016/B978-0-12-819304-4.00010-5
Wang W, Zhang C, Zheng W, Lv H, Li J, Liang B, Zhou W (2022) Seed priming with protein hydrolysate promotes seed germination via reserve mobilization, osmolyte accumulation and antioxidant systems under PEG-induced drought stress. Plant Cell Rep 41:2173–2186. https://doi.org/10.1007/s00299-022-02914-6
Wei J, Xu L, Shi Y, Cheng T, Tan W, Zhao Y, Li C, Yang X, Ouyang L, Wei M, Wang J, Lu G (2023) Transcriptome profile analysis of Indian mustard (Brassica juncea L.) during seed germination reveals the drought stress-induced genes associated with energy, hormone, and phenylpropanoid pathways. Plant Physiol Biochem 200:107750. https://doi.org/10.1016/j.plaphy.2023.107750
Xiao Z, Zou T, Lu S, Xu Z (2020) Soil microorganisms interacting with residue-derived allelochemicals effects on seed germination. Saudi J Biol Sci 27:1057–1065. https://doi.org/10.1016/j.sjbs.2020.01.013
Xu Z, Zuo L, Zhang Y, Huang R, Li L (2022) Is allelochemical synthesis in Casuarina equisetifolia plantation related to litter microorganisms? Front Plant Sci 13:1022984. https://doi.org/10.3389/fpls.2022.1022984
Yates RJ, Steel EJ, Edwards TJ, Harrison RJ, Hackney BF, Howieson JG (2024) Adverse consequences of herbicide residues on legumes in dryland agriculture. Field Crops Res 308:109271. https://doi.org/10.1016/j.fcr.2024.109271
Yonli D, Traore H, Kountche BA (2024) Weed and striga management in pearl millet production systems in Sub-saharan Africa. In: Tonapi VA, Thirunavukkarasu N, Gupta S, Gangashetty PI, Yadav O (eds) Pearl millet in the 21st century. Springer, Singapore. https://doi.org/10.1007/978-981-99-5890-0_15
Zareen S, Fawad M, Haroon M, Ahmad I, Zaman A (2022) Allelopathic potential of summer weeds on germination and growth performance of wheat and chickpea. J Nat Pesticide Res 1:100002. https://doi.org/10.1016/j.napere.2022.100002
Zelya IA, Anderson JAH, Owen MDK, Es RDL (2011) Evaluation of spectrophotometric and HPLC methods for shikimic acid determination in plants: models in glyphosate resistant and susceptible crops. J Agri Food Chem 59:2202–2212. https://doi.org/10.1021/jf1043426
Zhang X, Shen Y, Mu K, Cai W, Zhao Y, Shen H, Wang X, Ma H (2022) Phenylalanine ammonia Lyase GmPAL1.1 promotes seed vigor under high-temperature and -humidity stress and enhances seed germination under salt and drought stress in transgenic Arabidopsis Plants 11(23):3239. https://doi.org/10.3390/plants11233239
Author information
Authors and Affiliations
Corresponding author
Ethics declarations
Ethics approval and consent to participate
Not applicable.
Consent for publication
Not applicable.
Competing interests
We declare that we have no competing interests.
Additional information
Responsible Editor: Beatriz Vazquez-de-Aldana.
Publisher’s Note
Springer Nature remains neutral with regard to jurisdictional claims in published maps and institutional affiliations.
Supplementary Information
Below is the link to the electronic supplementary material.
Rights and permissions
Springer Nature or its licensor (e.g. a society or other partner) holds exclusive rights to this article under a publishing agreement with the author(s) or other rightsholder(s); author self-archiving of the accepted manuscript version of this article is solely governed by the terms of such publishing agreement and applicable law.
About this article
Cite this article
Al Hijab, L.Y.A., Albogami, A. & Naguib, D.M. Seed biopriming with soil microorganisms antagonize allelopathic effect of weeds residues on pearl millet germination. Plant Soil (2024). https://doi.org/10.1007/s11104-024-06640-8
Received:
Accepted:
Published:
DOI: https://doi.org/10.1007/s11104-024-06640-8